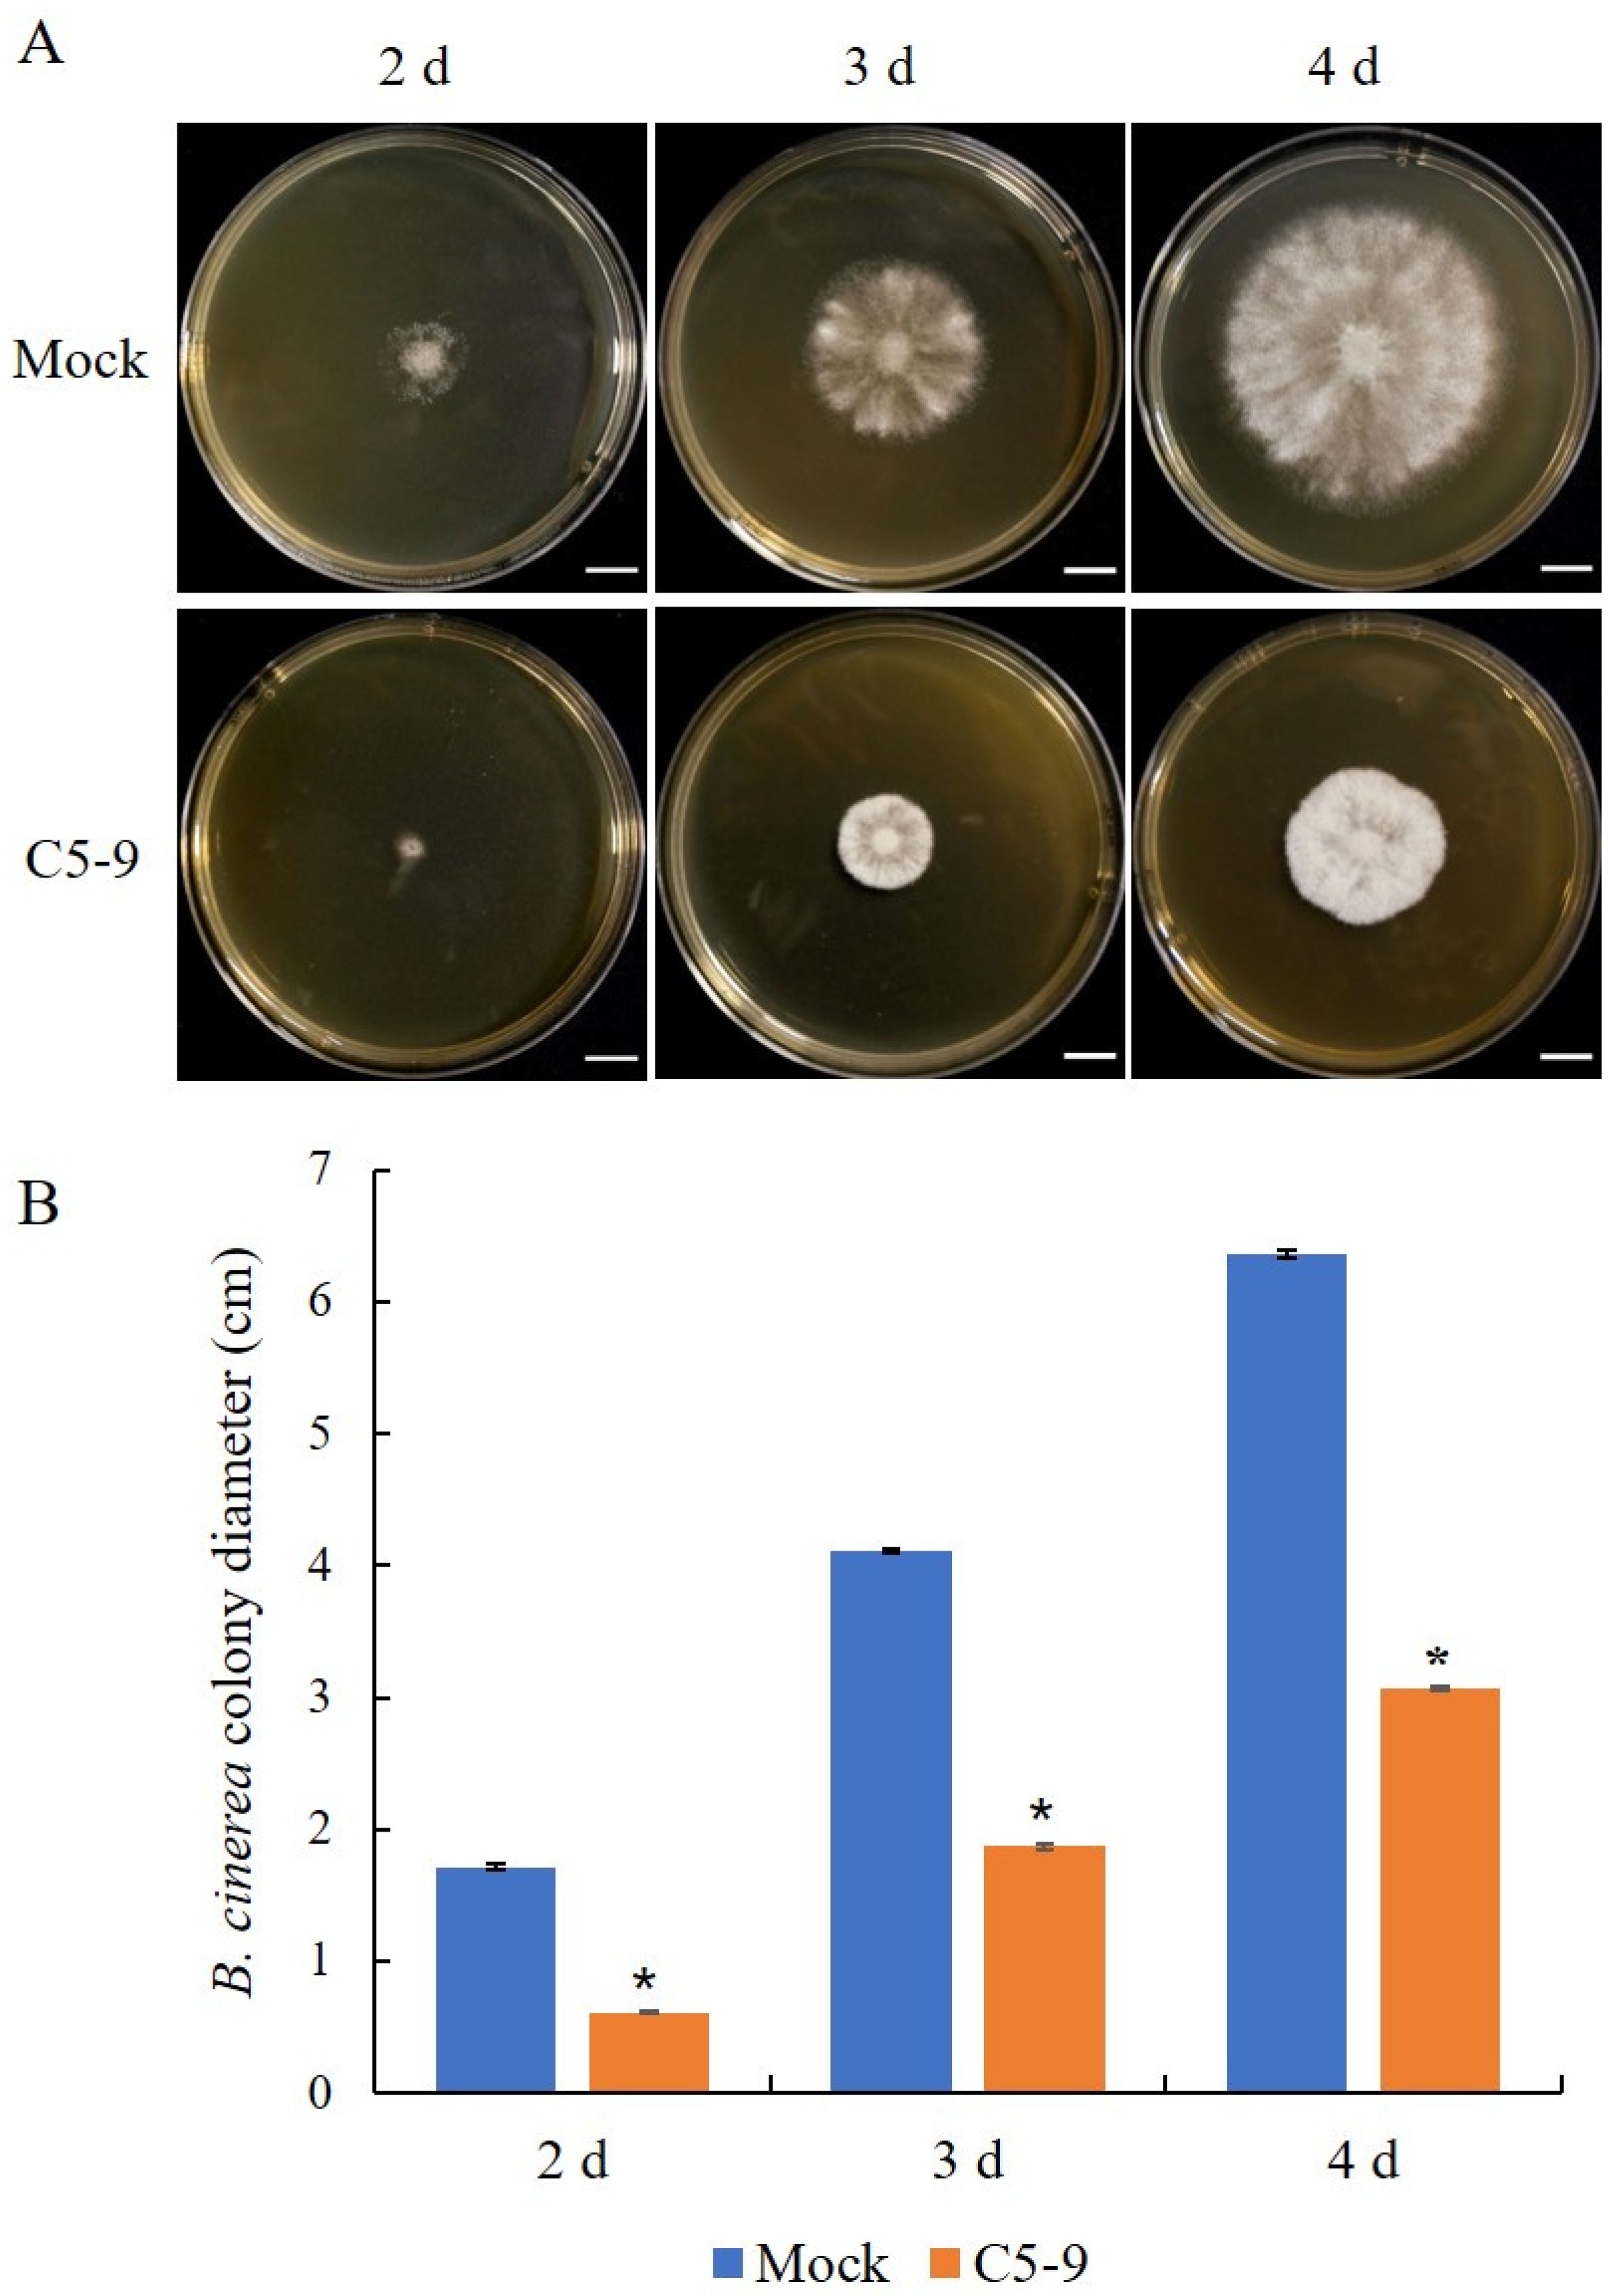
Microbiolres 14 00067 g003 Microbiolres 14 00067 g003

Transcriptome Analysis Deciphers Trichoderma koningiopsis C5-9 Strategies against Plant Pathogen Botrytis cinerea
Abstract
1. Introduction
2. Materials and Methods
2.1. Microorganism
2.2. Dual-Culture Assay
2.3. Molecular Identification of the C5-9 Strain
2.4. The Mycelial Growth Inhibition Experiment
2.5. Efficacy of T. koningiopsis C5-9 Fermentation Controlling B. cinerea in Cucumber
2.6. Preparation of Deactivated B. cinerea Mycelia and Cultivation of T. koningiopsis C5-9
2.7. Glucose Quantification
2.8. Transcriptome Analysis by RNA-Seq
2.9. Quantitative Reverse Transcriptase-PCR (qRT-PCR) Analysis
2.10. Statistical Analysis
3. Results
3.1. A Trichoderma Strain, C5-9, Was Isolated by Inhibiting B. cinerea under Low-Temperature Conditions
3.2. Morphological and Molecular Identification of Trichoderma C5-9
3.3. Antifungal Activity of the Fermentation Broth from the T. koningiopsis C5-9
3.4. T. koningiopsis C5-9 Could Utilize B. cinerea as a Carbon Source
3.5. Transcriptome Analysis Deciphering the Strategy of T. koningiopsis C5-9 Mycoparasitism against B. cinerea
3.6. Confirmation of Gene Expression by qRT-PCR
4. Discussion
4.1. T. koningiopsis C5-9 Is a Potential Biological Control Agent Inhibiting B. cinerea under Low-Temperature Conditions
4.2. Mycoparasitism Is Strain-Specific as a Conserved Biocontrol Mechanism in Trichoderma
4.3. Early Recognition of the Host Is Critical for Successful Trichoderma Actions
5. Conclusions
Supplementary Materials
Author Contributions
Funding
Data Availability Statement
Conflicts of Interest
References
- Bonfante, P.; Genre, A. Mechanisms underlying beneficial plant-fungus interactions in mycorrhizal symbiosis. Nat. Commun. 2010, 1, 48. [Google Scholar] [CrossRef] [PubMed]
- Kim, S.H.; Vujanovic, V. Relationship between mycoparasites lifestyles and biocontrol behaviors against Fusarium spp. and mycotoxins production. Appl. Microbiol. Biotechnol. 2016, 100, 5257–5272. [Google Scholar] [CrossRef]
- Thakur, R.; Srivastava, S.; Yadav, S. Multitrait Pseudomonas sp. isolated from the rhizosphere of Bergenia ciliata acts as a growth-promoting bioinoculant for plants. Front. Sustain. Food Syst. 2023, 7, 1097587. [Google Scholar] [CrossRef]
- Chandra, H.; Kumari, P.; Prasad, R.; Chandra Gupta, S.; Yadav, S. Antioxidant and antimicrobial activity displayed by a fungal endophyte Alternaria alternata isolated from Picrorhiza kurroa from Garhwal Himalayas, India. Biocatal. Agric. Biotechnol. 2021, 33, 101955. [Google Scholar] [CrossRef]
- Thakur, R.; Yadav, S. Thermotolerant and halotolerant Streptomyces sp. isolated from Ajuga parviflora having biocontrol activity against Pseudomonas syringae and Xanthomonas campestris acts as a sustainable bioadditive in growth promotion of Cicer arietinum. Physiol. Mol. Plant Pathol. 2023, 127, 102059. [Google Scholar] [CrossRef]
- Kubicek, C.P.; Herrera-Estrella, A.; Seidl-Seiboth, V.; Martinez, D.A.; Druzhinina, I.S.; Thon, M.; Zeilinger, S.; Casas-Flores, S.; Horwitz, B.A.; Mukherjee, P.K.; et al. Comparative genome sequence analysis underscores mycoparasitism as the ancestral life style of Trichoderma. Genome Biol. 2011, 12, R40. [Google Scholar] [CrossRef] [PubMed]
- Ramada, M.H.; Steindorff, A.S.; Bloch, C., Jr.; Ulhoa, C.J. Secretome analysis of the mycoparasitic fungus Trichoderma harzianum ALL 42 cultivated in different media supplemented with Fusarium solani cell wall or glucose. Proteomics 2016, 16, 477–490. [Google Scholar] [CrossRef] [PubMed]
- Atanasova, L.; Le Crom, S.; Gruber, S.; Coulpier, F.; Seidl-Seiboth, V.; Kubicek, C.P.; Druzhinina, I.S. Comparative transcriptomics reveals different strategies of Trichoderma mycoparasitism. BMC Genom. 2013, 14, 121. [Google Scholar] [CrossRef]
- You, J.; Li, G.; Li, C.; Zhu, L.; Yang, H.; Song, R.; Gu, W. Biological Control and Plant Growth Promotion by Volatile Organic Compounds of Trichoderma koningiopsis T-51. J. Fungi 2022, 8, 131. [Google Scholar] [CrossRef]
- Phoka, N.; Suwannarach, N.; Lumyong, S.; Ito, S.I.; Matsui, K.; Arikit, S.; Sunpapao, A. Role of Volatiles from the Endophytic Fungus Trichoderma asperelloides PSU-P1 in Biocontrol Potential and in Promoting the Plant Growth of Arabidopsis thaliana. J. Fungi 2020, 6, 341. [Google Scholar] [CrossRef]
- Oljira, A.M.; Hussain, T.; Waghmode, T.R.; Zhao, H.; Sun, H.; Liu, X.; Wang, X.; Liu, B. Trichoderma Enhances Net Photosynthesis, Water Use Efficiency, and Growth of Wheat (Triticum aestivum L.) under Salt Stress. Microorganisms 2020, 8, 1565. [Google Scholar] [CrossRef]
- Shoresh, M.; Harman, G.E.; Mastouri, F. Induced systemic resistance and plant responses to fungal biocontrol agents. Annu. Rev. Phytopathol. 2010, 48, 21–43. [Google Scholar] [CrossRef]
- Yuan, M.; Huang, Y.; Ge, W.; Jia, Z.; Song, S.; Zhang, L.; Huang, Y. Involvement of jasmonic acid, ethylene and salicylic acid signaling pathways behind the systemic resistance induced by Trichoderma longibrachiatum H9 in cucumber. BMC Genom. 2019, 20, 144. [Google Scholar] [CrossRef]
- Yang, H.H.; Yang, S.L.; Peng, K.C.; Lo, C.T.; Liu, S.Y. Induced proteome of Trichoderma harzianum by Botrytis cinerea. Mycol. Res. 2009, 113, 924–932. [Google Scholar] [CrossRef]
- Rocha, V.A.L.; Maeda, R.N.; Pereira, N.; Kern, M.F.; Elias, L.; Simister, R.; Steele-King, C.; Gómez, L.D.; McQueen-Mason, S.J. Characterization of the cellulolytic secretome of Trichoderma harzianum during growth on sugarcane bagasse and analysis of the activity boosting effects of swollenin. Biotechnol. Prog. 2016, 32, 327–336. [Google Scholar] [CrossRef]
- Sharma, V.; Salwan, R.; Sharma, P.N.; Kanwar, S.S. Elucidation of biocontrol mechanisms of Trichoderma harzianum against different plant fungal pathogens: Universal yet host specific response. Int. J. Biol. Macromol. 2017, 95, 72–79. [Google Scholar] [CrossRef]
- Herpoel-Gimbert, I.; Margeot, A.; Dolla, A.; Jan, G.; Molle, D.; Lignon, S.; Mathis, H.; Sigoillot, J.C.; Monot, F.; Asther, M. Comparative secretome analyses of two Trichoderma reesei RUT-C30 and CL847 hypersecretory strains. Biotechnol. Biofuels 2008, 1, 18. [Google Scholar] [CrossRef]
- Raza, W.; Ling, N.; Zhang, R.; Huang, Q.; Xu, Y.; Shen, Q. Success evaluation of the biological control of Fusarium wilts of cucumber, banana, and tomato since 2000 and future research strategies. Crit. Rev. Biotechnol. 2017, 37, 202–212. [Google Scholar] [CrossRef]
- Nawrocka, J.; Malolepsza, U.; Szymczak, K.; Szczech, M. Involvement of metabolic components, volatile compounds, PR proteins, and mechanical strengthening in multilayer protection of cucumber plants against Rhizoctonia solani activated by Trichoderma atroviride TRS25. Protoplasma 2018, 255, 359–373. [Google Scholar] [CrossRef]
- Dean, R.; Van Kan, J.A.; Pretorius, Z.A.; Hammond-Kosack, K.E.; Di Pietro, A.; Spanu, P.D.; Rudd, J.J.; Dickman, M.; Kahmann, R.; Ellis, J.; et al. The Top 10 fungal pathogens in molecular plant pathology. Mol. Plant Pathol. 2012, 13, 414–430. [Google Scholar] [CrossRef]
- Kanini, G.S.; Katsifas, E.A.; Savvides, A.L.; Hatzinikolaou, D.G.; Karagouni, A.D. Greek indigenous streptomycetes as biocontrol agents against the soil-borne fungal plant pathogen Rhizoctonia solani. J. Appl. Microbiol. 2013, 114, 1468–1479. [Google Scholar] [CrossRef]
- Li, Y.; Sun, R.; Yu, J.; Saravanakumar, K.; Chen, J. Antagonistic and Biocontrol Potential of Trichoderma asperellum ZJSX5003 Against the Maize Stalk Rot Pathogen Fusarium graminearum. Indian J. Microbiol. 2016, 56, 318–327. [Google Scholar] [CrossRef]
- Ruangwong, O.U.; Pornsuriya, C.; Pitija, K.; Sunpapao, A. Biocontrol Mechanisms of Trichoderma koningiopsis PSU3-2 against Postharvest Anthracnose of Chili Pepper. J. Fungi 2021, 7, 276. [Google Scholar] [CrossRef] [PubMed]
- Kim, J.J.; Kwon, Y.K.; Kim, J.H.; Heo, S.J.; Lee, Y.; Lee, S.J.; Shim, W.B.; Jung, W.K.; Hyun, J.H.; Kwon, K.K.; et al. Effective microwell plate-based screening method for microbes producing cellulase and xylanase and its application. J. Microbiol. Biotechnol. 2014, 24, 1559–1565. [Google Scholar] [CrossRef]
- Khalid, H.; Amin, F.R.; Chen, C. An integrated laboratory experiment for the determination of main components in different food samples. Biochem. Mol. Biol. Educ. 2022, 50, 133–141. [Google Scholar] [CrossRef] [PubMed]
- Mortazavi, A.; Williams, B.A.; McCue, K.; Schaeffer, L.; Wold, B. Mapping and quantifying mammalian transcriptomes by RNA-Seq. Nat. Methods 2008, 5, 621–628. [Google Scholar] [CrossRef]
- Fay, J.V.; Watkins, C.J.; Shrestha, R.K.; Litwiniuk, S.L.; Talavera Stefani, L.N.; Rojas, C.A.; Arguelles, C.F.; Ferreras, J.A.; Caccamo, M.; Miretti, M.M. Yerba mate (Ilex paraguariensis, A. St.-Hil.) de novo transcriptome assembly based on tissue specific genomic expression profiles. BMC Genom. 2018, 19, 891. [Google Scholar] [CrossRef]
- David, C.C.; Jacobs, D.J. Principal component analysis: A method for determining the essential dynamics of proteins. Methods Mol. Biol. 2014, 1084, 193–226. [Google Scholar] [CrossRef]
- Singh, C.; Roy-Chowdhuri, S. Quantitative Real-Time PCR: Recent Advances. Methods Mol. Biol. 2016, 1392, 161–176. [Google Scholar] [CrossRef]
- Mishra, P.; Singh, U.; Pandey, C.M.; Mishra, P.; Pandey, G. Application of student’s t-test, analysis of variance, and covariance. Ann. Card Anaesth. 2019, 22, 407–411. [Google Scholar] [CrossRef]
- Liu, Q.; Wang, L. t-Test and ANOVA for data with ceiling and/or floor effects. Behav. Res. Methods 2021, 53, 264–277. [Google Scholar] [CrossRef] [PubMed]
- Zhu, L.; Qian, N.; Sun, Y.; Lu, X.; Duan, H.; Qian, L. Pseudomonas fluorescens DN16 Enhances Cucumber Defense Responses Against the Necrotrophic Pathogen Botrytis cinerea by Regulating Thermospermine Catabolism. Front. Plant Sci. 2021, 12, 645338. [Google Scholar] [CrossRef] [PubMed]
- Yang, Y.; Wang, X.; Chen, P.; Zhou, K.; Xue, W.; Abid, K.; Chen, S. Redox Status, JA and ET Signaling Pathway Regulating Responses to Botrytis cinerea Infection Between the Resistant Cucumber Genotype and Its Susceptible Mutant. Front. Plant Sci. 2020, 11, 559070. [Google Scholar] [CrossRef]
- Liu, Q.; Liu, P.; Xu, Y.; Wang, B.; Liu, P.; Hao, J.; Liu, X. Encapsulation of fluazinam to extend efficacy duration in controlling Botrytis cinerea on cucumber. Pest Manag. Sci. 2021, 77, 2836–2842. [Google Scholar] [CrossRef]
- Liu, M.; Zhang, Q.; Wang, C.; Meng, T.; Wang, L.; Chen, C.; Ren, Z. CsWRKY10 mediates defence responses to Botrytis cinerea infection in Cucumis sativus. Plant Sci. Int. J. Exp. Plant Biol. 2020, 300, 110640. [Google Scholar] [CrossRef]
- Vos, C.M.; De Cremer, K.; Cammue, B.P.; De Coninck, B. The toolbox of Trichoderma spp. in the biocontrol of Botrytis cinerea disease. Mol. Plant Pathol. 2015, 16, 400–412. [Google Scholar] [CrossRef]
- Pieterse, C.M.; Zamioudis, C.; Berendsen, R.L.; Weller, D.M.; Van Wees, S.C.; Bakker, P.A. Induced systemic resistance by beneficial microbes. Annu. Rev. Phytopathol. 2014, 52, 347–375. [Google Scholar] [CrossRef]
- Harman, G.E. Overview of Mechanisms and Uses of Trichoderma spp. Phytopathology 2006, 96, 190–194. [Google Scholar] [CrossRef]
- Dubey, M.; Jensen, D.F.; Karlsson, M. Functional characterization of the AGL1 aegerolysin in the mycoparasitic fungus Trichoderma atroviride reveals a role in conidiation and antagonism. Mol. Genet. Genom. 2021, 296, 131–140. [Google Scholar] [CrossRef]
- Wang, R.; Chen, D.; Khan, R.A.A.; Cui, J.; Hou, J.; Liu, T. A novel Trichoderma asperellum strain DQ-1 promotes tomato growth and induces resistance to gray mold caused by Botrytis cinerea. FEMS Microbiol. Lett. 2021, 368, fnab140. [Google Scholar] [CrossRef]
- Qualhato, T.F.; Lopes, F.A.; Steindorff, A.S.; Brandao, R.S.; Jesuino, R.S.; Ulhoa, C.J. Mycoparasitism studies of Trichoderma species against three phytopathogenic fungi: Evaluation of antagonism and hydrolytic enzyme production. Biotechnol. Lett. 2013, 35, 1461–1468. [Google Scholar] [CrossRef] [PubMed]
- Alfiky, A. Effects of ultraviolet irradiation on the in vitro antagonistic potential of Trichoderma spp. against soil-borne fungal pathogens. Heliyon 2019, 5, e02111. [Google Scholar] [CrossRef] [PubMed]
- Hirpara, D.G.; Gajera, H.P. Molecular heterozygosity and genetic exploitations of Trichoderma inter-fusants enhancing tolerance to fungicides and mycoparasitism against Sclerotium rolfsii Sacc. Infect. Genet. Evol. 2018, 66, 26–36. [Google Scholar] [CrossRef] [PubMed]
- Ries, L.; Pullan, S.T.; Delmas, S.; Malla, S.; Blythe, M.J.; Archer, D.B. Genome-wide transcriptional response of Trichoderma reesei to lignocellulose using RNA sequencing and comparison with Aspergillus niger. BMC Genom. 2013, 14, 541. [Google Scholar] [CrossRef]
- Reithner, B.; Ibarra-Laclette, E.; Mach, R.L.; Herrera-Estrella, A. Identification of mycoparasitism-related genes in Trichoderma atroviride. Appl. Environ. Microbiol. 2011, 77, 4361–4370. [Google Scholar] [CrossRef]
- Mukherjee, P.K.; Horwitz, B.A.; Herrera-Estrella, A.; Schmoll, M.; Kenerley, C.M. Trichoderma research in the genome era. Annu. Rev. Phytopathol. 2013, 51, 105–129. [Google Scholar] [CrossRef]
- Moreno-Ruiz, D.; Salzmann, L.; Fricker, M.D.; Zeilinger, S.; Lichius, A. Stress-Activated Protein Kinase Signalling Regulates Mycoparasitic Hyphal-Hyphal Interactions in Trichoderma atroviride. J. Fungi 2021, 7, 365. [Google Scholar] [CrossRef] [PubMed]

Disclaimer/Publisher’s Note: The statements, opinions and data contained in all publications are solely those of the individual author(s) and contributor(s) and not of MDPI and/or the editor(s). MDPI and/or the editor(s) disclaim responsibility for any injury to people or property resulting from any ideas, methods, instructions or products referred to in the content. |
© 2023 by the authors. Licensee MDPI, Basel, Switzerland. This article is an open access article distributed under the terms and conditions of the Creative Commons Attribution (CC BY) license (https://creativecommons.org/licenses/by/4.0/).
Share and Cite
Yuan, M.; Zuo, C.; Xu, W.; Zhang, L.; Guo, X.; Yan, X.; Li, S.; Li, Y.; Zhang, L.; Geng, J.; et al. Transcriptome Analysis Deciphers Trichoderma koningiopsis C5-9 Strategies against Plant Pathogen Botrytis cinerea. Microbiol. Res. 2023, 14, 977-992. https://doi.org/10.3390/microbiolres14030067
Yuan M, Zuo C, Xu W, Zhang L, Guo X, Yan X, Li S, Li Y, Zhang L, Geng J, et al. Transcriptome Analysis Deciphers Trichoderma koningiopsis C5-9 Strategies against Plant Pathogen Botrytis cinerea. Microbiology Research. 2023; 14(3):977-992. https://doi.org/10.3390/microbiolres14030067
Chicago/Turabian StyleYuan, Min, Chunliu Zuo, Wen Xu, Li Zhang, Xinyue Guo, Xinyue Yan, Songyang Li, Yanling Li, Lan Zhang, Jiaqi Geng, and et al. 2023. "Transcriptome Analysis Deciphers Trichoderma koningiopsis C5-9 Strategies against Plant Pathogen Botrytis cinerea" Microbiology Research 14, no. 3: 977-992. https://doi.org/10.3390/microbiolres14030067
APA StyleYuan, M., Zuo, C., Xu, W., Zhang, L., Guo, X., Yan, X., Li, S., Li, Y., Zhang, L., Geng, J., & Huang, Y. (2023). Transcriptome Analysis Deciphers Trichoderma koningiopsis C5-9 Strategies against Plant Pathogen Botrytis cinerea. Microbiology Research, 14(3), 977-992. https://doi.org/10.3390/microbiolres14030067
